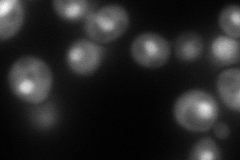
YGL207W
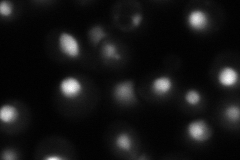
YGL207W

View description
Subunit of the heterodimeric FACT complex (Spt16p-Pob3p), facilitates RNA Polymerase II transcription elongation through nucleosomes by destabilizing and then reassembling nucleosome structure
Localization:
Intensity:
Fold change:
Significance:
-
C’ GFP library in SD

nucleus127.67 -
N' NOP1pr-GFP in SD

below threshold0 -
N' TEF2pr-mCherry in SD
nucleus172.546 -
N' NATIVEpr-GFP in SD
nucleus90.2854 -
N' TEF2pr-VC and Cyto-VN in SD

#N/A0 -
C’ GFP library in SD+DTT

nucleus107.260.84No -
C’ GFP library in SD+H2O2

nucleus137.481.07No -
C’ GFP library in Starvation Media

nucleus92.640.72No -
C’ GFP library on the background of Pup2-DaMP

nucleus -
C’ GFP library on the background of CCT mutant

nucleus131.9561.0335No
